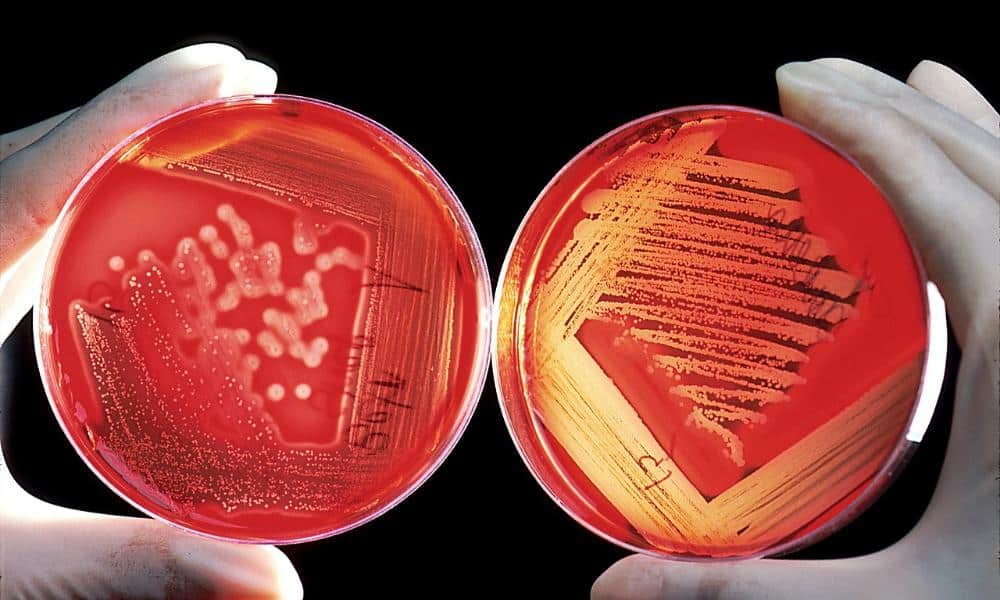
Materiały odporne na ekstremalne warunki – przyszłość inżynierii i technologii

Materiały odporne na ekstremalne warunki – przyszłość inżynierii i technologii
Wyobraź sobie samolot lecący przez burzę piaskową, sondę kosmiczną badającą powierzchnię Wenus lub samochód sportowy pędzący po torze z prędkością 300 km/h. Co łączy te wszystkie scenariusze? W każdym z nich kluczową rolę odgrywają materiały zdolne wytrzymać ekstremalne warunki – wysokie temperatury, intensywne tarcie, promieniowanie czy działanie agresywnych chemikaliów.
Naukowcy od lat pracują nad stworzeniem substancji, które sprostają najtrudniejszym wyzwaniom. W jaki sposób są projektowane? Gdzie znajdują zastosowanie? Jakie przełomowe odkrycia czekają na nas w przyszłości? Sprawdźmy, jak wygląda świat materiałów ekstremalnie wytrzymałych.
Materiały, które wytrzymają wszystko – kluczowe cechy
Aby dany materiał mógł być uznany za odporny na ekstremalne warunki, musi spełniać określone kryteria. Do najważniejszych cech należą:
✅ Odporność na wysokie temperatury – materiały stosowane w przemyśle lotniczym czy kosmicznym muszą wytrzymać tysiące stopni Celsjusza.
✅ Twardość i wytrzymałość mechaniczna – odporność na ścieranie, uderzenia i naprężenia jest kluczowa np. w turbinach silników odrzutowych.
✅ Stabilność chemiczna – materiały muszą być odporne na działanie kwasów, zasad czy promieniowania jonizującego.
✅ Lekkość – szczególnie istotna w zastosowaniach lotniczych i kosmicznych, gdzie każda redukcja masy przekłada się na wydajność.
Te właściwości są osiągane dzięki nowoczesnym technologiom i unikalnym metodom obróbki materiałów.
Przełomowe materiały odporne na ekstremalne warunki
Ceramika ultrawysokotemperaturowa (UHTC)
Jednym z największych przełomów w inżynierii materiałowej są ceramiki ultrawysokotemperaturowe. Powstają na bazie związków boru, węgla i azotu. Przykłady to:
- Zirkon boru (ZrB₂) – wytrzymuje temperatury dochodzące do 3500°C.
- Węglik hafnu (HfC) – stosowany w osłonach termicznych pojazdów kosmicznych.
Te materiały mają kluczowe znaczenie w eksploracji kosmosu, gdzie temperatury podczas wejścia w atmosferę mogą sięgać kilku tysięcy stopni.
Aerogele – superlekkie, ale ekstremalnie wytrzymałe
Aerogele to jedne z najlżejszych materiałów na świecie. Są zbudowane głównie z powietrza (nawet 99% objętości), ale jednocześnie zapewniają doskonałą izolację termiczną. NASA wykorzystuje je do ochrony elektroniki w sondach kosmicznych.
Stopy tytanu – wytrzymałość i lekkość w jednym
Tytan i jego stopy, takie jak Ti-6Al-4V, charakteryzują się znakomitym stosunkiem wytrzymałości do masy oraz odpornością na korozję. Znajdują zastosowanie w przemyśle lotniczym, medycynie (implanty) oraz motoryzacji.
Gdzie stosuje się materiały odporne na ekstremalne warunki?
Nowoczesne materiały zmieniają oblicze wielu branż. Oto najważniejsze obszary zastosowań:
🔹 Przemysł lotniczy i kosmiczny – osłony termiczne, kadłuby rakiet, elementy silników odrzutowych.
🔹 Energetyka jądrowa – powłoki ochronne w reaktorach, osłony przed promieniowaniem.
🔹 Motoryzacja i sport motorowy – elementy układu wydechowego, tarcze hamulcowe, nadwozia samochodów wyścigowych.
🔹 Elektronika – półprzewodniki odporne na wysokie temperatury w satelitach i misjach kosmicznych.
Największe wyzwania w badaniach nad nowymi materiałami
Mimo ogromnych postępów, naukowcy wciąż mierzą się z wieloma trudnościami:
🔸 Koszty produkcji – zaawansowane materiały są często niezwykle drogie.
🔸 Łączność materiałów – znalezienie sposobu na trwałe połączenie ekstremalnie wytrzymałych substancji to duże wyzwanie.
🔸 Odporność na długotrwałe obciążenia – niektóre materiały tracą swoje właściwości po dłuższym czasie użytkowania w ekstremalnych warunkach.
Rozwiązaniem tych problemów mogą być nowe technologie, takie jak druk 3D metali i ceramiki, pozwalający na precyzyjne kształtowanie struktur odpornych na wysokie temperatury.
Jakie materiały przyszłości zmienią świat?
Naukowcy już teraz pracują nad przełomowymi rozwiązaniami. Oto kilka obiecujących innowacji:
📌 Samonaprawiające się metale – materiały zdolne do regeneracji mikrouszkodzeń bez interwencji człowieka.
📌 Superhydrofobowe powłoki – materiały odpychające wodę i zabrudzenia, przydatne np. w lotnictwie i motoryzacji.
📌 Metamateriały – struktury, które manipulują światłem i falami dźwiękowymi, otwierając drogę do niewidzialności optycznej.
Co dalej? Jakie są kierunki badań?
Przyszłość badań nad materiałami odpornymi na ekstremalne warunki zapowiada się fascynująco. Dzięki sztucznej inteligencji i komputerowym symulacjom możliwe jest projektowanie nowych struktur na poziomie atomowym.
Jeśli chcesz śledzić najnowsze innowacje, warto zwracać uwagę na prace instytutów badawczych oraz doniesienia z laboratoriów NASA, ESA czy MIT.
Nowe materiały zmieniają świat – od przestrzeni kosmicznej po codzienne przedmioty. Kto wie, może wkrótce smartfony będą miały ekrany odporne na pęknięcia, a samochody wykonane z ultralekkich, niezniszczalnych stopów?


